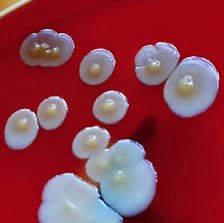
this is a colony of bacteria
yes it looks delicious
yes i want to eat it

Lila Maria 🌳🌼 DAY/BREAK
@lila_daybreak
Member of VTuber/VSinger group @DAYBREAK_twt 🇵🇭 drawing&FPS┆ママ@vivirasuto┆🎀 地下アイドル大好き 🎁throne.com/lilamaria 🎨#Lilandscape 🤪#Lilasdfghjkl
ID: 1068168029081620480
http://youtube.com/@Lila_DAYBREAK 29-11-2018 15:41:18
12,12K Tweet
3,3K Takipçi
1,1K Takip Edilen












DAY/BREAK // PH VSinger-VTuber GROUP #FraizeBeToSerina Lila Maria 🌳🌼 DAY/BREAK #valerisus Raian Valerius ⚜️🔥 Knight VTuber #illustraian Serina Fraize ✨ DAY/BREAK #Lilasdfghjkl